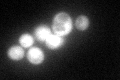
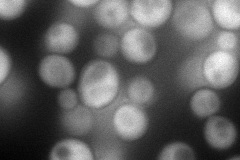
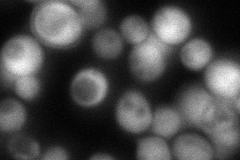
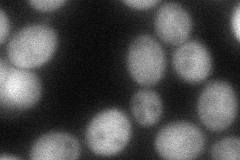
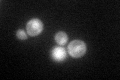

View description
Imidazole glycerol phosphate synthase (glutamine amidotransferase:cyclase), catalyzes the fifth and sixth steps of histidine biosynthesis and also produces 5-aminoimidazole-4-carboxamide ribotide (AICAR), a purine precursor
Localization:
Intensity:
Fold change:
Significance:
-
C’ GFP library in SD
cytosol117.41 -
N' NOP1pr-GFP in SD
cytosol140.7 -
N' TEF2pr-mCherry in SD

cytosol173.061 -
N' NATIVEpr-GFP in SD
cytosol119.067 -
N' TEF2pr-VC and Cyto-VN in SD
cytosol72.376 -
C’ GFP library in SD+DTT

cytosol82.310.7No -
C’ GFP library in SD+H2O2

cytosol138.911.18No -
C’ GFP library in Starvation Media
cytosol99.620.84No -
C’ GFP library on the background of Pup2-DaMP

cytosol -
C’ GFP library on the background of CCT mutant

cytosol135.8041.15658No
